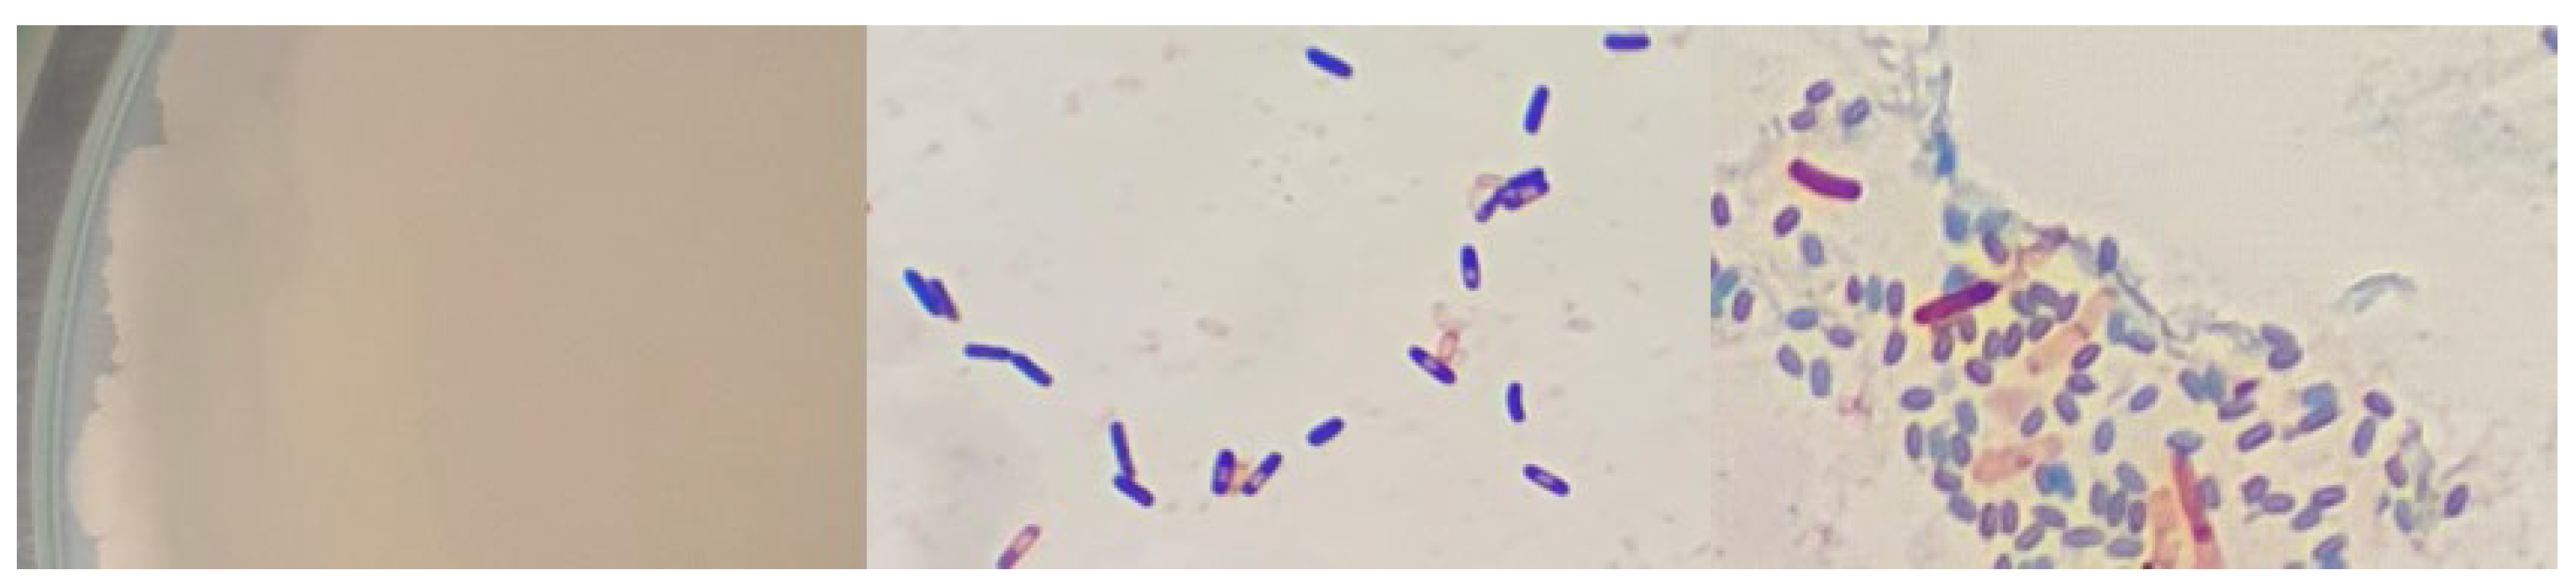
Microorganisms 12 01066 g0a13

Isolation and Characterization of Thermophilic Bacteria from a Hot Spring in the State of Hidalgo, Mexico, and Geochemical Analysis of the Thermal Water
Abstract
1. Introduction
2. Materials and Methods
2.1. Sampling and Physicochemical Characterization of Water
2.2. Hydrogeochemical Analysis
2.3. Isolation and Characterization of the Isolated Strains
2.3.1. Microscopic Observation
2.3.2. Morphological Characterization
2.3.3. Physiological Characterization
2.3.4. Biochemical Characterization
Sugar Fermentation, Hydrogen Sulfide, and Gas Production
Indole Test
Catalase Activity
Casein Hydrolysis
Starch Hydrolysis
Gelatin Hydrolysis
Cellulose, Pectin, and Xylan Hydrolysis
2.4. Molecular Identification of the Isolated Strains
3. Results
3.1. Physicochemical Characterization of Hot Spring Water
3.2. Hydrogeochemical Analysis
3.3. Characterization of the Isolated Strains
3.3.1. Microscopic Observation
3.3.2. Morphological Characterization of the Isolated Strains
3.3.3. Physiological Characterization of the Isolated Strains
3.3.4. Biochemical Characterization of the Isolated Strains
3.4. Molecular Identification of the Isolated Strains
4. Discussion
4.1. Physicochemical Characterization of Thermal Water
4.2. Hydrogeochemical Analysis
4.3. Characterization of the Isolated Strains
4.4. Molecular Identification of the Isolated Strains
5. Conclusions
Author Contributions
Funding
Data Availability Statement
Acknowledgments
Conflicts of Interest
Appendix A

References
- Maier, R.M.; Neilson, J.W. Extreme Environments. In Environmental Microbiology, 3rd ed.; Pepper, I.L., Gerba, C.P., Gentry, T.J., Eds.; Academic Press: Millbrae, CA, USA, 2015; pp. 139–153. [Google Scholar] [CrossRef]
- Seckbach, J. Life on the edge and astrobiology: Who is who in the polyextremophiles world? In Polyextremophiles, 1st ed.; Seckbach, J., Oren, A., Stan-Lotter, H., Eds.; Springer: Dordrecht, The Netherlands, 2013; Volume 27, pp. 61–79. [Google Scholar] [CrossRef]
- Merino, N.; Aronson, H.S.; Bojanova, D.P.; Feyhl-Buska, J.; Wong, M.L.; Zhang, S.; Giovannelli, D. Living at the extremes: Extremophiles and the limits of the life in a planetary context. Front. Microbiol. 2019, 19, 780. [Google Scholar] [CrossRef] [PubMed]
- Aanniz, T.; Ouadghiri, M.; Melloul, M.; Swings, J.; Elfahime, E.; Ibijbijen, J.; Ismaili, M.; Amar, M. Thermophilic bacteria in Moroccan hot springs, salt marshes and desert soils. Braz. J. Microbiol. 2015, 46, 443–453. [Google Scholar] [CrossRef] [PubMed]
- Ghosh, S.; Lepcha, K.; Basak, A.; Mahanty, K.A. Thermophiles and thermophilic hydrolases. In Physiological and Biotechnological Aspects of Extremophiles; Salwan, R., Sharma, V., Eds.; Academic Press: London, UK, 2020; pp. 219–236. [Google Scholar] [CrossRef]
- Von Hegner, I. Extremophiles: A special or general case in the search for extra-terrestrial life? Extremophiles 2019, 24, 167–175. [Google Scholar] [CrossRef] [PubMed]
- Mehta, R.; Singhal, P.; Singh, H.; Damle, D.; Sharma, A.K. Insight into thermophiles and their wide-spectrum applications. 3 Biotech 2016, 6, 2–9. [Google Scholar] [CrossRef] [PubMed]
- Arya, M.; Joshi, G.K.; Kumar Gupta, A.; Kumar, A.; Raturi, A. Isolation and characterization of thermophilic bacterial strains from Soldhar (Tapovan) hot springs in central Himalayan region, India. Ann. Microbiol. 2015, 65, 1457–1464. [Google Scholar] [CrossRef]
- Mohammad, T.B.; Al Daghistani, I.H.; Jaouani, A.; Abdel-Latif, S.; Kennes, C. Isolation and characterization of thermophilic bacteria from Jordania hot springs: Bacillus licheniformis and Thermomonas hydrothermalis isolates as potential producers of thermostable enzymes. Int. J. Microbiol. 2017, 2017, 6943952. [Google Scholar] [CrossRef]
- Benammar, L.; Bektaş, I.K.; Menasria, T.; Beldüz, A.O.; Güler, I.H.; Bedaida, I.K.; Gonzalez, J.M.; Ayachi, A. Diversity and enzymatic potential of thermophilic bacteria associated with terrestrial hot springs in Algeria. Braz. J. Microbiol. 2020, 51, 1987–2007. [Google Scholar] [CrossRef] [PubMed]
- Fontana, A.; De Filippis, V.; Polverino de Laureto, P.; Scaramella, E.; Zambonin, M. Rigidity of thermophilic enzymes. In Progress in Biotechnology; Ballesteros, A., Plou, F.J., Iborra, J.L., Halling, P.J., Eds.; Elsevier: Cordoba, Spain, 1998; Volume 15, pp. 277–294. [Google Scholar] [CrossRef]
- Gomes, E.; Rodrigues de Souza, A.; Ladino Orjuelas, G.; Da Silva, R.; Brito de Oliveira, T.; Rodrigues, A. Applications and benefits of thermophilic microorganisms and their enzymes for industrial biotechnology. In Gene Expression Systems in Fungi: Advancements and Applications; Schmoll, M., Dattenböck, C., Eds.; Springer: Cham, Switzerland, 2016; pp. 459–492. [Google Scholar] [CrossRef]
- Abdollahi, P.; Ghane, M.; Babaeekhou, L. Isolation and characterization of thermophilic bacteria from Gavmesh Goli hot spring in Sabalan geothermal field, Iran: Thermomonas hydrothermalis and Bacillus altitudinis isolates as a potential source of thermostable protease. Geomicrobiol. J. 2020, 38, 87–95. [Google Scholar] [CrossRef]
- Wemheuer, B.; Taube, R.; Akyol, P.; Wemheuer, F.; Daniel, R. Microbial diversity and biochemical potential encoded by thermal springs metagenomes derived from the Kamchatka Peninsula. Archaea 2013, 2013, 136714. [Google Scholar] [CrossRef]
- Escuder-Rodríguez, J.J.; DeCastro, M.E.; Becerra, M.; Rodríguez-Belmonte, E.; González-Siso, M.I. Advances of functional metagenomics in harnessing thermozymes. In Metagenomics, Perspectives, Methods, and Applications; Nagarajan, M., Ed.; Academic Press: London, UK, 2018; pp. 289–307. [Google Scholar] [CrossRef]
- Li, L.; Ma, Z. Global microbiome diversity scaling in hot springs with DAR (Diversity-Area Relationship) profiles. Front. Microbiol. 2019, 10, 431426. [Google Scholar] [CrossRef]
- McCall, G.J.H. Geysers and hot springs. In Encyclopedia of Geology; Selley, R.C., Cocks, L.R.M., Plimer, I.R., Eds.; Academic Press: Oxford, UK, 2005; Volume 3, pp. 105–117. [Google Scholar] [CrossRef]
- Chalise, B.; Paudyal, P.; Bahadur Kunwar, B.; Bishwakarma, K.; Thapa, B.; Raj Pant, R.; Bhakta Neupane, B. Water quality and hydrochemical assessments of thermal springs, Gandaki Province, Nepal. Heliyon 2023, 9, 1–15. [Google Scholar] [CrossRef] [PubMed]
- Yang, F.; Li, D.; Zhou, X.; Zhan, T.; Ma, Y.; Wang, X.; Dong, J.; Liu, L.; Shi, Y.; Su, Y. Microbial community composition in thermal waters from the Lindian geothermal field (Songliao Basin, North-Eastern China). Water 2022, 14, 632. [Google Scholar] [CrossRef]
- Glazier, D.S. Springs. In Encyclopedia of Inland Waters; Likens, G.E., Ed.; Academic Press: Oxford, UK, 2014; pp. 1–78. [Google Scholar] [CrossRef]
- Cuecas, A.; Portillo, M.C.; Kanoksilapatham, W.; Gonzalez, J.M. Bacterial distribution along a 50 °C temperature gradient reveals a parceled out hot spring environment. Microb. Ecol. 2014, 68, 729–739. [Google Scholar] [CrossRef] [PubMed]
- Gharwalová, L.; Palyzová, A.; Marešová, H.; Kolouchová, I.; Kyselová, L.; Řezanka, T. Identification of homologous polyprenols from thermophilic bacteria. Microorganisms 2021, 9, 1168. [Google Scholar] [CrossRef] [PubMed]
- Thankappan, S.; Kandasamy, S.; Joshi, B.; Sorokina, N.K.; Taran, O.P.; Uthandi, S. Bioprospecting thermophilic glycosyl hydrolases, from hot springs of Himachal Pradesh, for biomass valorization. AMB Express 2018, 8, 168. [Google Scholar] [CrossRef] [PubMed]
- SGM. Volcanes de México. Available online: https://www.sgm.gob.mx/Web/MuseoVirtual/Riesgos-geologicos/Volcanes-de-Mexico.html (accessed on 30 January 2024).
- GHS. Grupo de Hidrología Subterránea. EasyQuim.4. Available online: https://h2ogeo.upc.edu (accessed on 13 November 2023).
- Moreno Merino, L.; Aguilera Alonso, H.; González Jiménez, M.; Díaz Lozada, E.; Romero Prados, A. D-Piper (Diagrama Piper de Densidad) Representación de Grandes Conjuntos de Datos Mediante el Diagrama de Piper, Manual de uso; Publicaciones del Instituto Geológico y Minero de España: Madrid, Spain, 2021; pp. 1–40. [Google Scholar]
- Parkhurst, D.L.; Appelo, C.A.J. Description of Input and Examples for PHREEQC Version 3—A Computer Program for Speciation, Batch-Reaction, One-Dimensional Transport, and Inverse Geochemical Calculations; Techniques and Method; U.S. Geological Survey: Denver, CO, USA, 2013; 497p. Available online: https://pubs.usgs.gov/tm/06/a43/pdf/tm6-A43.pdf (accessed on 7 November 2023).
- Gram Stain Protocols. Available online: https://asm.org/protocols/gram-stain-protocols (accessed on 25 April 2023).
- Endospore Stain. Available online: https://asm.org/protocols/endospore-stain-protocol (accessed on 25 April 2023).
- Smith, J.M. Cultural Characteristics. Microbiological Applications, Laboratory Manual in General Microbiology, 8th ed.; McGraw Hill Higher Education: New York, NY, USA, 2002; pp. 157–160. [Google Scholar]
- De Vos, P.; Garrity, G.M.; Jones, D.; Krieg, N.R.; Ludwig, W.; Rainey, F.A.; Schleifer, K.-H.; Whitman, W.B. The Firmicutes. Bergey’s Manual of Systematic Bacteriology, 2nd ed.; Springer: Dordrecht, The Netherlands, 2009; pp. 1–1476. [Google Scholar]
- Alexander, S.K.; Strete, D. Microbiology: A Photographic Atlas for the Laboratory; Benjamin Cummings: York, PA, USA, 2001; pp. 88–90. [Google Scholar]
- Indole Test. Available online: https://asm.org/protocols/indole-test-protocol (accessed on 25 April 2023).
- Catalase Test. Available online: https://asm.org/protocols/catalase-test-protocol (accessed on 25 April 2023).
- Casein Hydrolysis. Available online: https://asm.org/image-gallery/casein-hydrolysis (accessed on 25 April 2023).
- Starch Agar. Available online: https://asm.org/protocols/starch-agar-protocol (accessed on 25 April 2023).
- Gelatin Hydrolysis Test. Available online: https://asm.org/protocols/gelatin-hydrolysis-test-protocol (accessed on 25 April 2023).
- Santiago-Hernandez, A.; Vega-Estrada, J.; del Carmen Montes-Horcasitas, M.; Hidalgo-Lara, M.E. Purification and characterization of two sugarcane bagasse-absorbable thermophilic xylanases from the mesophilic Cellulomonas flavigena. J. Ind. Microbiol. Biotechnol. 2007, 34, 331–338. [Google Scholar] [CrossRef] [PubMed]
- Kasana, R.C.; Salwan, R.; Dhar, H.; Dutt, S.; Gulati, A. A rapid and easy method for the detection of microbial cellulases on agar plates using gram’s iodine. Curr. Microbiol. 2008, 57, 503–507. [Google Scholar] [CrossRef] [PubMed]
- Actividades Hidrolíticas y Caracterización Isoenzimática de Poblaciones Microbianas Aisladas del Patrimonio Documental del Archivo General de Colombia. Available online: https://revistas.unicolmayor.edu.co/index.php/nova/article/view/22 (accessed on 25 April 2023).
- Cayetano-Cruz, M.; Pérez de los Santos, A.I.; García-Huante, Y.; Santiago-Hernández, A.; Pavón-Orozco, P.; López y López, V.E.; Hidalgo-Lara, M.E. High level expression of a recombinant xylanase by Pichia pastoris cultured in a bioreactor with methanol as the sole carbon source: Purification and biochemical characterization of the enzyme. Biochem. Eng. J. 2016, 112, 161–169. [Google Scholar] [CrossRef]
- Weisburg, W.G.; Barns, S.M.; Pelletier, D.A.; Lane, D.J. 16S Ribosomal DNA amplification for phylogenetic study. J. Bacteriol. 1991, 173, 697–703. [Google Scholar] [CrossRef] [PubMed]
- BLAST. Available online: https://blast.ncbi.nlm.nih.gov/Blast.cgi?PROGRAM=blastn&PAGE_TYPE=BlastSearch&LINK_LOC=blasthome (accessed on 16 October 2023).
- Tamura, K.; Stecher, G.; Kumar, S. MEGA 11: Molecular Evolutionary Genetics Analysis version 11. MBE 2021, 38, 3022–3027. [Google Scholar] [CrossRef]
- Clasificación de Yacimientos Minerales. Available online: https://www.sgm.gob.mx/Web/MuseoVirtual/Aplicaciones_geologicas/Clasificacion-de-yacimientos-minerales.html (accessed on 13 November 2023).
- Piñeiro Ramírez, D.H. Inventario Físico de los Recursos Minerales de la Carta Actopan F14-D71, Municipios de Actopan, Atotonilco el Grande, Mineral del Chico, Metztitlán y Santiago de Anaya, Estado de Hidalgo; Servicio Geológico Mexicano: Pachuca, Mexico, 2011; pp. 1–105. [Google Scholar]
- Saz, P.; Gálvez, J.J.; Ortiz, M.; Saz, S. Agua y Salud, Balnoterapia. Ámbito Farm. Salud Integral 2011, 30, 66–70. Available online: https://www.elsevier.es/es-revista-offarm-4-pdf-X0212047X11622831 (accessed on 13 May 2023).
- Subtavewung, P.; Raksaskulwong, M.; Tulyatid, J. The characteristics of hot springs in Thailand. In Proceedings of the World Geothermal, Antalaya, Turkey, 24–29 April 2005; Available online: https://www.geothermal-energy.org/pdf/IGAstandard/WGC/2005/0845.pdf (accessed on 23 September 2023).
- Camargo Cruz, T.; Núñez Benítez, J.; Ángeles Hernández, J.G. Atotonilco El Grande, Santa María Amajac. Aguas termales del Estado de Hidalgo; Universidad Autónoma del Estado de Hidalgo: Pachuca, Mexico, 2022; pp. 36–39. [Google Scholar]
- Krieger, R.A. The chemistry of saline waters. Groundwater 1964, 2, 51. [Google Scholar] [CrossRef]
- Krieger, R.A. The chemistry of saline waters. Groundwater 1963, 1, 7–12. [Google Scholar] [CrossRef]
- Pazdro, Z.; Kozerski, B. Hydrogeologia Ogólna, 4th ed.; Wydawnictwa Geologiczne: Warszawa, Poland, 1990; 624p. [Google Scholar]
- Porowski, A. Mineral and Thermal Waters. In Environmental Geology; LaMoreaux, J., Ed.; Springer: New York, NY, USA, 2019; pp. 149–181. [Google Scholar] [CrossRef]
- Rupasinghe, R.; Amarasena, S.; Wickramarathna, S.; Biggs, P.J.; Chandrajith, R.; Wickramasinghe, S. Microbial diversity and ecology of geothermal springs in the high-grade metamorphic terrain of Sri Lanka. Environ. Adv. 2022, 7, 100166. [Google Scholar] [CrossRef]
- Chan, C.S.; Chan, K.-G.; Ee, R.; Hong, K.-W.; Urbieta, M.S.; Donati, E.R.; Shamsir, M.S.; Goh, K.M. Effects of physiochemical factors on prokaryotic biodiversity in Malaysian circumneutral hot springs. Front. Microbiol. 2017, 8, 275979. [Google Scholar] [CrossRef]
- Lee, Y.-J.; Ganbat, D.; Oh, D.; Kim, H.; Jeong, G.E.; Cha, I.-T.; Kim, S.-B.; Nam, G.; Jung, Y.-L.; Lee, S.-J. Isolation and characterization of thermophilic bacteria from hot springs in Republic of Korea. Microorganisms 2022, 10, 2375. [Google Scholar] [CrossRef]
- Prieto-Barajas, C.M.; Alfaro-Cuevas, R.; Valencia-Cantero, E.; Santoyo, G. Effect of seasonality and physicochemical parameters on bacterial communities in two hot springs microbial mats from Araró, Mexico. Rev. Mex. Biodivers. 2017, 88, 616–624. [Google Scholar] [CrossRef]
- Nabi Najar, I.; Thundu Sherpa, M.; Das, S.; Das, S.; Thakur, N. Microbial ecology of two hot springs of Sikkim: Predominate population and geochemistry. Sci. Total Environ. 2018, 637–638, 730–745. [Google Scholar] [CrossRef]
- Bratcher, J.C.; Kaszuba, J.P.; Herz-Thyhsen, R.J.; Dewey, J.C. Ionic strength and pH effects on water-rock interaction in an unconventional siliceous reservoir: On the use of formation water in hydraulic fracturing. Energy Fuels 2021, 35, 18414–18429. [Google Scholar] [CrossRef]
- Arellano-Gil, J.; Velasco-de-León, P.; Silva-Pineda, A.; Salvador-Flores, R.; Beltrán-Romero, F. Origen y características geológicas del paleo-Lago de Amajac, Hidalgo. Rev. Mex. Cienc. Geol. 2005, 22, 199–211. [Google Scholar]
- van Teeseling, M.C.F.; de Pedro, M.A.; Cava, F. Determinants of bacterial morphology: From fundamentals to possibilities for antimicrobial targeting. Front. Microbiol. 2017, 8, 278838. [Google Scholar] [CrossRef]
- Young, K.D. Bacterial morphology: Why have different shapes? Curr. Opin. Microbiol. 2007, 10, 596–600. [Google Scholar] [CrossRef]
- Kumar, R.; Sharma, R.C. Microbial diversity in relation to physico-chemical properties of hot water ponds located in the Yamunotri landscape of Garhwal Himalaya. Heliyon 2020, 6, 1–9. [Google Scholar] [CrossRef]
- Colony Morphology of Bacteria. Available online: https://microbeonline.com/colony-morphology-bacteria-describe-bacterial-colonies/ (accessed on 7 March 2024).
- Ali Akond, M.; Jahan, M.N.; Sultana, N.; Rahman, F. Effect of temperature, pH and NaCl on the isolates of Actinomycetes from straw and compost samples from Savar, Dhaka, Banglades. Am. J. Microbiol. Immunol. 2016, 1, 10–15. [Google Scholar]
- Sharma, S.; Vaid, S.; Bhat, B.; Singh, S.; Kumar Bajaj, B. Thermostable enzymes for industrial biotechnology. In Advances in Enzyme Technology; Sarup Singh, R., Rani Singhania, R., Pandey, A., Larroche, C., Eds.; Elsevier: Amsterdam, The Netherlands, 2019; pp. 469–495. [Google Scholar] [CrossRef]
- Atalah, J.; Cáceres-Moreno, P.; Espina, G.; Blamey, J.M. Thermophiles and the applications of their enzymes as new biocatalysts. Bioresour. Technol. 2019, 280, 478–488. [Google Scholar] [CrossRef]
- Patel, K.; Dudhagara, P. Optimization of xylanase production by Bacillus tequilensis strain UD-3 using economical agricultural substrate and its applications in rice straw pulp bleaching. Biocatal. Agric. Biotechnol. 2020, 30, 101846. [Google Scholar] [CrossRef]
- Bouraoui, H.; Ben Aissa, M.; Abbassi, F.; Pierre Touzel, J.; O´donohue, M.; Manai, M. Characterization of Deinococcus sahariens sp. Nov., a radiation-resistant bacterium isolated from a Saharan hot spring. Arch. Microbiol. 2012, 194, 315–322. [Google Scholar] [CrossRef]



| Parameters | Units | Z1 | Z2 |
|---|---|---|---|
| Dissolved oxygen | mg/L | 4.00 | 2.45 |
| pH | pH | 6.76 | 6.73 |
| Temperature | °C | 44.74 | 53.77 |
| Electrical conductivity | μS/cm | 3170 | 2778 |
| Total dissolved solids | mg/L | 1585 | 1389 |
| Salinity | PSU | 1.60 | 1.37 |
| Redox | mV | 226.8 | 248.8 |
| Parameters | Concentration (mg/L) |
|---|---|
| Ca2+ | 234.12 |
| Mg2+ | 41.67 |
| Na+ | 114.25 |
| K+ | 11.72 |
| PO43− | 1.87 |
| NO₃− | 0 |
| CO32− | 0 |
| HCO3− | 203.79 |
| Cl− | 13.37 |
| SO42− | 895.95 |
| Hardness | 729.23 |
| Electrical conductivity | 2651 * |
| Effective salinity | 8.698 |
| Morphology | Z1 | Z2 | |||||||||||||||||
|---|---|---|---|---|---|---|---|---|---|---|---|---|---|---|---|---|---|---|---|
| 1 | 2 | 3 | 4 | 5 | 6 | 7 | 1 | 2 | 3 | 4 | 5 | 6 | 7 | 8 | 9 | 10 | 11 | ||
| Agar plate | |||||||||||||||||||
| Shape | Round | + | + | + | + | + | + | ||||||||||||
| Rhizoid | + | + | + | + | |||||||||||||||
| Amoeboid | + | + | + | + | + | + | + | + | |||||||||||
| Margin | Undulate | + | + | + | + | + | + | ||||||||||||
| Lobate | + | + | + | + | + | + | + | ||||||||||||
| Entire | + | + | |||||||||||||||||
| Serrate | + | + | + | ||||||||||||||||
| Elevation | Flat | + | + | + | + | + | + | + | + | + | + | + | + | ||||||
| Rough | + | + | + | + | |||||||||||||||
| Papillate | + | + | |||||||||||||||||
| Texture | Butyrous | + | + | + | + | + | + | + | + | + | + | + | |||||||
| Membranous | + | + | + | + | + | + | |||||||||||||
| Viscid | + | ||||||||||||||||||
| Color | Beige | + | + | + | + | + | + | + | + | + | |||||||||
| White | + | + | + | + | + | + | + | ||||||||||||
| Yellow | + | ||||||||||||||||||
| Orange | + | ||||||||||||||||||
| Agar deep tubes | |||||||||||||||||||
| Morphology | Papillate | + | + | + | + | + | + | + | + | + | + | + | + | + | + | ||||
| Beaded | + | ||||||||||||||||||
| Filiform | + | + | + | ||||||||||||||||
| Agar slant tubes | |||||||||||||||||||
| Morphology | Echinulate | + | + | + | + | + | + | + | |||||||||||
| Rhizoid | + | + | + | + | + | ||||||||||||||
| Filiform | + | + | + | + | |||||||||||||||
| Effuse | + | ||||||||||||||||||
| Beaded | + | ||||||||||||||||||
| Liquid media | |||||||||||||||||||
| Superficial growth | Membranous | + | + | + | + | + | + | + | + | + | + | + | + | ||||||
| Flocculent | + | + | + | ||||||||||||||||
| Ring | + | ||||||||||||||||||
| No growth | + | + | |||||||||||||||||
| Turbid | Light | + | + | + | + | + | + | + | + | ||||||||||
| Medium | + | ||||||||||||||||||
| Null | + | ||||||||||||||||||
| Transient | + | + | + | + | + | + | + | + | |||||||||||
| Sediment | Viscid | + | + | + | + | + | + | + | + | + | + | + | |||||||
| Lumpy | + | + | |||||||||||||||||
| Granular | + | + | + | + | + | ||||||||||||||
| Quantity of sediment | Abundant | + | + | + | + | ||||||||||||||
| Scanty | + | + | + | + | + | + | + | + | + | + | + | + | + | + | |||||
| Tolerance Test | Z1 | Z2 | |||||||||||||||||
|---|---|---|---|---|---|---|---|---|---|---|---|---|---|---|---|---|---|---|---|
| 1 | 2 | 3 | 4 | 5 | 6 | 7 | 1 | 2 | 3 | 4 | 5 | 6 | 7 | 8 | 9 | 10 | 11 | ||
| T | 25 °C | -- | * | * | * | * | * | * | * | * | * | * | * | * | * | * | * | * | * |
| 37 °C | * | * | + | + | * | + | + | + | + | + | * | + | + | * | + | + | + | * | |
| 50 °C | * | + | + | + | * | + | + | * | + | + | * | + | * | * | * | * | * | * | |
| 60 °C | * | + | + | + | * | + | + | * | + | + | * | + | + | * | * | -- | * | - | |
| pH | 5 | -- | -- | -- | -- | ° | ° | -- | ° | ° | ° | ° | ° | ° | ° | ° | ° | -- | * |
| 6 | -- | -- | -- | ° | ° | ° | -- | * | ° | * | * | + | * | ° | * | + | + | * | |
| 7 | * | + | + | + | * | + | * | ° | * | + | * | * | * | * | ° | ° | ° | * | |
| 8 | -- | * | * | * | ° | * | ° | ° | ° | ° | * | * | ° | ° | ° | ° | ° | ° | |
| 9 | -- | + | + | + | * | + | + | + | * | + | * | + | + | + | + | ° | * | ° | |
| NaCl | 2% | * | + | + | + | * | * | + | + | + | + | * | + | + | * | * | ° | + | - |
| 5% | * | + | + | + | -- | + | + | + | + | + | ° | ° | + | ° | * | + | + | * | |
| 7% | ° | + | ° | + | ° | + | + | ° | ° | ° | ° | ° | ° | ° | ° | ° | ° | -- | |
| Biochemical Test | Z1 | Z2 | Control | ||||||||||||||||||
|---|---|---|---|---|---|---|---|---|---|---|---|---|---|---|---|---|---|---|---|---|---|
| 1 | 2 | 3 | 4 | 5 | 6 | 7 | 1 | 2 | 3 | 4 | 5 | 6 | 7 | 8 | 9 | 10 | 11 | C- | C+ | ||
| F | Glucose | - | - | + | + | - | + | + | + | + | + | - | + | + | + | + | + | + | - | + | + |
| Lactose | - | - | + | - | - | - | - | - | - | - | - | + | - | + | - | - | - | - | + | + | |
| Sucrose | - | - | + | - | - | - | - | - | - | - | - | + | . | + | - | - | - | - | + | + | |
| P | H2S | - | - | - | - | - | - | - | - | - | - | - | - | - | + | - | - | - | - | - | - |
| Gas | - | - | - | - | - | - | - | - | - | - | - | - | - | - | - | - | - | - | + | - | |
| A | Indole | - | - | - | - | - | - | - | - | - | - | - | - | - | - | - | - | - | - | + | - |
| Catalase | - | + | + | + | + | + | + | + | + | + | + | + | + | + | + | + | + | + | - | + | |
| H | Casein | + | + | + | + | + | + | + | + | - | + | + | + | + | + | + | + | + | + | - | + |
| Starch | - | + | - | - | - | + | + | + | + | - | - | + | + | - | - | - | + | - | - | + | |
| Gelatin | - | + | + | + | + | + | + | + | + | + | - | + | + | + | + | + | + | - | - | + | |
| Cellulose | - | + | + | + | - | + | + | + | + | + | - | + | + | + | + | + | + | - | - | - | |
| Pectin | - | - | + | + | - | + | + | - | - | - | - | + | - | - | - | - | - | - | - | - | |
| Xylan | - | - | - | - | - | - | - | + | + | + | - | - | + | - | - | - | + | - | - | - | |
| Strain | Bp | Identity | Gen Bank Accession Number | Per Ident | Query Cover | E Value |
|---|---|---|---|---|---|---|
| Z1-1 | 1428 | Anoxybacillus gonensis strain G2, complete genome | PP579944 | 99.86% | 99% | 0.0 |
| Z1-2 | 1397 | Bacillus licheniformis strain Ba2 16S rRNA | PP579945 | 100% | 100% | 0.0 |
| Z1-3 | 1400 | Bacillus licheniformis strain ZBT15 16S rRNA | PP579946 | 97.34% | 99% | 0.0 |
| Z1-4 | 1396 | Bacillus licheniformis strain ASMK2 16S rRNA | PP579947 | 97.86% | 100% | 0.0 |
| Z1-5 | 1418 | Bacillus licheniformis strain ASMK2 16S rRNA | PP579948 | 97.46% | 99% | 0.0 |
| Z1-6 | 1422 | Bacillus licheniformis strain RFNB2 16S rRNA | PP579949 | 97.40% | 100% | 0.0 |
| Z1-7 | 1398 | Bacillus licheniformis strain TB212 16S rRNA | PP579950 | 100% | 100% | 0.0 |
| Z2-1 | 1383 | Aneurinibacillus sp. Bac270 16S rRNA | PP579951 | 99.78% | 100% | 0.0 |
| Z2-2 | 1403 | Bacillus tequilensis strain SQA-76 16S rRNA | PP579952 | 100% | 100% | 0.0 |
| Z2-3 | 1400 | Bacillus tequilensis strain KHJP1 16S rRNA | PP579953 | 97.43% | 100% | 0.0 |
| Z2-4 | 1384 | Bacillus sp. L-bf-R2A-30.3 16S rRNA | PP579954 | 99.78% | 99% | 0.0 |
| Z2-5 | 1416 | Bacillus licheniformis strain Ba2 16S rRNA | PP579955 | 99.22% | 100% | 0.0 |
| Z2-6 | 1396 | Bacillus subtilis strain ZG13-41 16S rRNA | PP579956 | 100% | 100% | 0.0 |
| Z2-7 | 1399 | Paenibacillus dendritiformis strain ClaCZ2 16S 16S rRNA | PP579957 | 100% | 100% | 0.0 |
| Z2-8 | 1422 | Paenibacillus dendritiformis strain ClaCZ203 16S 16S rRNA | PP579958 | 99.44% | 100% | 0.0 |
| Z2-9 | 1419 | Bacillus licheniformis strain KaK2A 16S rRNA | PP579959 | 99.37% | 100% | 0.0 |
| Z2-10 | 1403 | Bacillus subtilis strain 3667 16S rRNA | PP579960 | 99.93% | 100% | 0.0 |
| Z2-11 | 1350 | Deinococcus sahariens strain HAN23 16S 16S rRNA | PP579961 | 99.04% | 100% | 0.0 |
Disclaimer/Publisher’s Note: The statements, opinions and data contained in all publications are solely those of the individual author(s) and contributor(s) and not of MDPI and/or the editor(s). MDPI and/or the editor(s) disclaim responsibility for any injury to people or property resulting from any ideas, methods, instructions or products referred to in the content. |
© 2024 by the authors. Licensee MDPI, Basel, Switzerland. This article is an open access article distributed under the terms and conditions of the Creative Commons Attribution (CC BY) license (https://creativecommons.org/licenses/by/4.0/).
Share and Cite
Ortega-Villar, R.; Escalante, A.; Astudillo-Melgar, F.; Lizárraga-Mendiola, L.; Vázquez-Rodríguez, G.A.; Hidalgo-Lara, M.E.; Coronel-Olivares, C. Isolation and Characterization of Thermophilic Bacteria from a Hot Spring in the State of Hidalgo, Mexico, and Geochemical Analysis of the Thermal Water. Microorganisms 2024, 12, 1066. https://doi.org/10.3390/microorganisms12061066
Ortega-Villar R, Escalante A, Astudillo-Melgar F, Lizárraga-Mendiola L, Vázquez-Rodríguez GA, Hidalgo-Lara ME, Coronel-Olivares C. Isolation and Characterization of Thermophilic Bacteria from a Hot Spring in the State of Hidalgo, Mexico, and Geochemical Analysis of the Thermal Water. Microorganisms. 2024; 12(6):1066. https://doi.org/10.3390/microorganisms12061066
Chicago/Turabian StyleOrtega-Villar, Rosangel, Adelfo Escalante, Fernando Astudillo-Melgar, Liliana Lizárraga-Mendiola, Gabriela A. Vázquez-Rodríguez, María Eugenia Hidalgo-Lara, and Claudia Coronel-Olivares. 2024. "Isolation and Characterization of Thermophilic Bacteria from a Hot Spring in the State of Hidalgo, Mexico, and Geochemical Analysis of the Thermal Water" Microorganisms 12, no. 6: 1066. https://doi.org/10.3390/microorganisms12061066
APA StyleOrtega-Villar, R., Escalante, A., Astudillo-Melgar, F., Lizárraga-Mendiola, L., Vázquez-Rodríguez, G. A., Hidalgo-Lara, M. E., & Coronel-Olivares, C. (2024). Isolation and Characterization of Thermophilic Bacteria from a Hot Spring in the State of Hidalgo, Mexico, and Geochemical Analysis of the Thermal Water. Microorganisms, 12(6), 1066. https://doi.org/10.3390/microorganisms12061066

